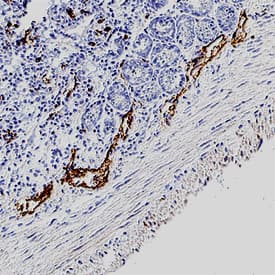
LYVE-1 antibody in Mouse Intestine by Immunohistochemistry (IHC-Fr).

Mouse LYVE-1 Antibody
R&D Systems, part of Bio-Techne | Catalog # MAB2125


Key Product Details
Species Reactivity
Validated:
Cited:
Applications
Validated:
Cited:
Label
Antibody Source
Product Specifications
Immunogen
Ala24-Thr234
Accession # Q8BHC0
Specificity
Clonality
Host
Isotype
Endotoxin Level
Scientific Data Images for Mouse LYVE-1 Antibody
Detection of Mouse LYVE‑1 by Western Blot.
Western blot shows lysate of bEnd.3 mouse endothelioma cell line. PVDF membrane was probed with 2 µg/mL of Rat Anti-Mouse LYVE-1 Monoclonal Antibody (Catalog # MAB2125) followed by HRP-conjugated Anti-Rat IgG Secondary Antibody (HAF005). A specific band was detected for LYVE-1 at approximately 65 kDa (as indicated). This experiment was conducted under non-reducing conditions and using Immunoblot Buffer Group 1.Detection of LYVE‑1 in bEnd.3 Mouse Cell Line by Flow Cytometry.
bEnd.3 mouse endothelioma cell line was stained with Rat Anti-Mouse LYVE-1 Monoclonal Antibody (Catalog # MAB2125, filled histogram) or isotype control antibody (MAB006, open histogram), followed by Phycoerythrin-conjugated Anti-Rat IgG Secondary Antibody (F0105B).LYVE-1 in NS0 mouse myeloma cell line transfected with mouse LYVE-1.
LYVE-1 was detected in immersion fixed NS0 mouse myeloma cell line transfected with mouse LYVE-1 (positive control) and wild type NS0 mouse myeloma cell line (negative control) using Rat Anti-Mouse LYVE-1 Monoclonal Antibody (Catalog # MAB2125) at 8 µg/mL for 3 hours at room temperature. Cells were stained using the NorthernLights™ 557-conjugated Anti-Rat IgG Secondary Antibody (red; NL013) and counterstained with DAPI (blue). Specific staining was localized to cytoplasm. View our protocol for Fluorescent ICC Staining of Non-adherent Cells.Applications for Mouse LYVE-1 Antibody
CyTOF-ready
Flow Cytometry
Sample: bEnd.3 mouse endothelioma cell line
Immunocytochemistry
Sample: Immersion fixed NS0 mouse myeloma cell line transfected with mouse LYVE-1
Immunohistochemistry
Sample: Immersion fixed frozen sections of mouse intestine tissue
Western Blot
Sample: bEnd.3 mouse endothelioma cell line under non-reducing conditions only
Reviewed Applications
Read 3 reviews rated 5 using MAB2125 in the following applications:
Formulation, Preparation, and Storage
Purification
Reconstitution
Formulation
*Small pack size (-SP) is supplied either lyophilized or as a 0.2 µm filtered solution in PBS.
Shipping
Stability & Storage
- 12 months from date of receipt, -20 to -70 °C as supplied.
- 1 month, 2 to 8 °C under sterile conditions after reconstitution.
- 6 months, -20 to -70 °C under sterile conditions after reconstitution.
Background: LYVE-1
Lymphatic vessel endothelial hyaluronan (HA) receptor-1 (LYVE-1) is a recently identified receptor of HA, a linear high molecular weight polymer composed of alternating units of D-glucuronic acid and N-acetyl-D-glucosamine. HA is found in the extracellular matrix of most animal tissues and in body fluids. It modulates cell behavior and functions during tissue remodeling, development, homeostasis, and disease (1). The turnover of HA (several grams/day in humans) occurs primarily in the lymphatics and liver, the two major clearance systems that catabolize approximately 85% and 15% of HA, respectively (1-3). LYVE-1 shares 41% homology with the other known HA receptor, CD44 (4). The homology between the two proteins increases to 61% within the HA binding domain. The HA binding domain, known as the link module, is a common structural motif found in other HA binding proteins such as link protein, aggrecan and versican (1, 5). Human and mouse LYVE-1 share 69% amino acid sequence identity.
LYVE-1 is primarily expressed on both the luminal and abluminal surfaces of lymphatic vessels (4, 5). In addition, LYVE-1 is also present in normal hepatic blood sinusoidal endothelial cells (6). LYVE-1 mediates the endocytosis of HA and may transport HA from tissue to lymph by transcytosis, delivering HA to lymphatic capillaries for removal and degradation in the regional lymph nodes (5, 7, 8). Because of its restricted expression patterns, LYVE-1, along with other lymphatic proteins such as VEGF R3, podoplanin and the homeobox protein propero-related (Prox-1), constitute a set of markers useful for distinguishing between lymphatic and blood microvasculature (4, 5, 9-11).
References
- Knudson, C.B. and W. Knudson (1993) FASEB J. 7:1233.
- Evered, D. and J. Whelan (1989) Ciba Found. Symp. 143:1.
- Laurent, T.C. and J.R.F. Fraser (1992) FASEB J. 6:2397.
- Banerji, S. et al. (1999) J. Cell Biol. 144:789.
- Prevo, R. et al. (2001) J. Biol. Chem. 276:19420.
- Carreira, C.M. et al. (2001) Cancer Research 61:8079.
- Jackson, D.J. et al. (2001) Trends Immunol. 22:317.
- Zhou, B. et al. (2000) J. Biol. Chem. 275:37733.
- Achen, M. et al. (1998) Proc. Natl. Acad. Sci. USA 95:548.
- Breiteneder-Gellef, S. et al. (1999) Am. J. Pathol. 154:385.
- Wiggle, J.T. and G. Oliver (1999) Cell 98:769.
Long Name
Alternate Names
Gene Symbol
UniProt
Additional LYVE-1 Products
Product Documents for Mouse LYVE-1 Antibody
Product Specific Notices for Mouse LYVE-1 Antibody
For research use only